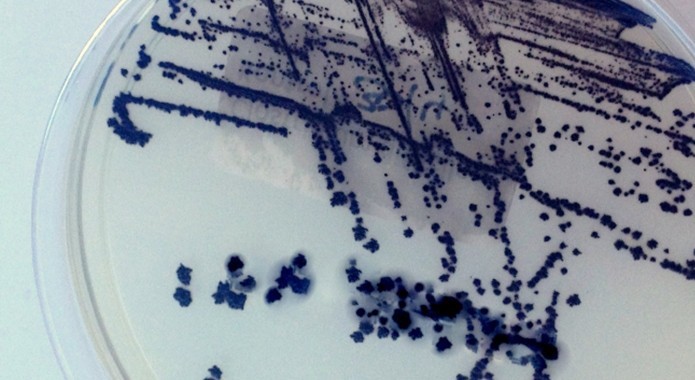

Clostridium difficile infection (CDI) is a highly symptomatic, rarely tested bacterial infection that is responsible for 3,700 deaths in Europe each year.
The infection causes abdominal cramping, diarrhea, fever, mucus or blood in stool, and elevated white blood cell levels. In Europe, half of all hospitals will only test for the infection if the physician specifically requests it, which is part of the reason almost two-thirds of cases go undetected.
When doctors do ask for the testing, many hospitals are ill-equipped, lacking the most current testing procedure for CDI. This misdiagnosis results in an estimated $3.23 billion a year in additional testing and hospital stays. If the testing does not improve, the cost is estimated to double over the next 40 years.
To combat this problem, medical organizations in Europe are coming out with new guidelines for screening. A new recommendation from the European Society of Clinical Microbiology and Infectious Diseases (ESCMID) is testing all unformed stool samples in patients over 3 with symptoms and a follow-up Toxin A/B test to confirm the diagnosis.
In the United States, hospitals use molecular tests to diagnose the infection, but they are leaning toward implementing ESCMID’s guidelines. In the U.S., approximately 30,000 people die each year from C. difficile which is only 2,000 fewer than are killed in traffic accidents.